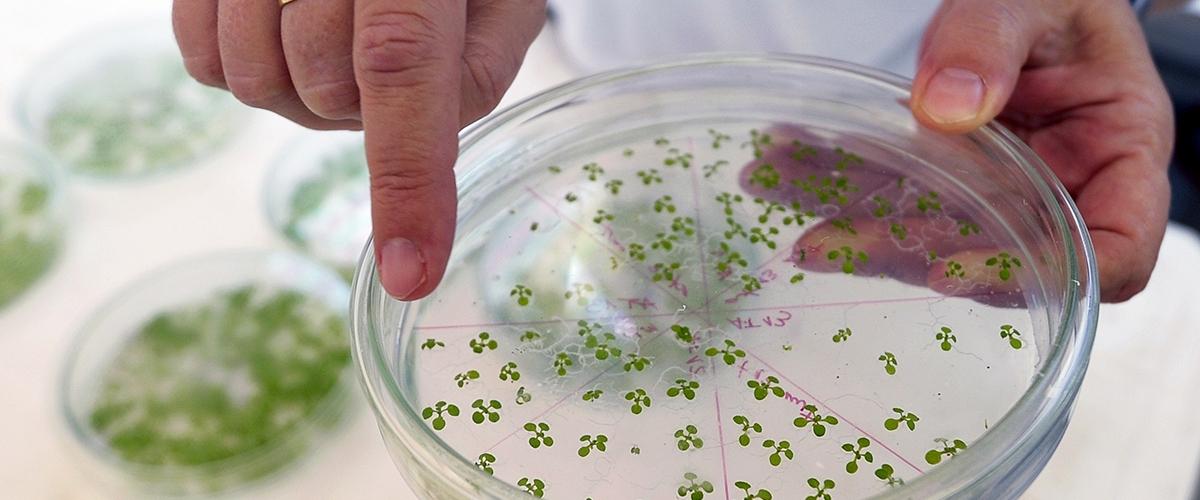

Как и животным, растениям необходимо отражать атаки вирусов и бактерий, однако до сих пор иммунная система растений была плохо изучена. Исследователи из Университета штата Вашингтон, о работе которых рассказывает Futurism, разобрались, как именно она работает.
В основе защитной системы растений лежит молекула АТФ, или аденозин-5-трифосфат, важнейший компонент внутриклеточного метаболизма. За пределами клеток АТФ служит сигнальной молекулой, которая запускает иммунный ответ при вторжении чужеродных микроорганизмов.
Ученые запустили у растений иммунный ответ, а затем проследили путь сигнала до химических рецепторов. Это позволило составить карту химических реакций, с помощью которых растения реагируют на инфекции.
По мнению авторов работы, их исследования позволят создавать сорта, устойчивые к определенным видам болезней и вредителей.